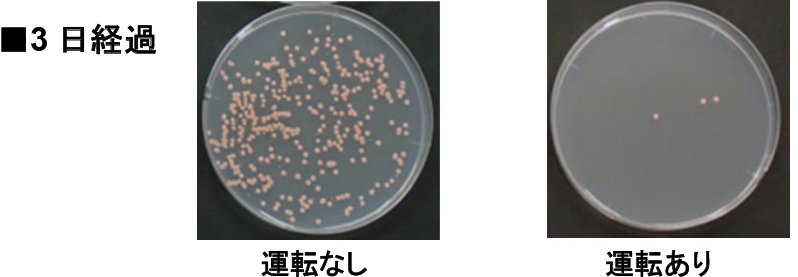
ピンクぬめりの原因菌を除菌

壁掛型浴室暖房乾燥機をモデルチェンジ 10月1日発売
湯はり運転と連動した浴室暖房運転でヒートショック対策 プラズマクラスター技術搭載でピンクぬめり原因菌の除菌
今回のモデルチェンジでは暖房の連動運転や換気の自動運転を可能とし、省エネやヒートショック対策に貢献します。また、プラズマクラスターイオンの濃度を高め、浴室内で懸念されるピンクぬめりの原因菌の除菌や、洋服に付着したタバコ臭の消臭などの効果が期待でき、日々の中での面倒なお掃除や困り事を解決します。
 RBH-W415シリーズ
RBH-W415シリーズ
浴室暖房乾燥機(壁掛型) RBH-W415シリーズ
発売日 2023年10月1日
希望小売価格 税込121,000円 (税抜110,000円)~
新商品の特長
暖房の連動運転や換気の自動運転が可能な便利機能搭載
1)暖房の自動連動
給湯暖房用熱源機の台所リモコンで浴室暖房機能を「自動」に設定すれば、自動湯はりの際、浴室が15℃以下の時だけ浴室暖房が連動して運転を開始します。※2
冷え込みやすい浴室をあたためることは、ヒートショック対策に効果的です。寒い日だけ湯はり時に自動で暖房運転を行うため、リビングと浴室の寒暖差を意識せずとも安心して入浴が可能です。
 暖房機能仕様前後の室温比較
暖房機能仕様前後の室温比較
2)換気運転自動コース
自動コースで換気運転を開始すると、湿度センサーが浴室内の湿度を検知し、湿度が低くなると自動で運転を停止します。
水分たっぷりの湿気と浴室独特のイヤなにおいを排出し空気をリフレッシュすることができます。
 換気運転自動コース
換気運転自動コース
従来機種※3よりイオン濃度の高い『プラズマクラスター25000』を搭載
プラズマクラスターイオンの濃度を高め、高い空気浄化力が期待できます。※4
 プラズマクラスター25000
プラズマクラスター25000
1)ピンクぬめりの原因菌を除菌※5し、浴室掃除の負担を軽減
平均25,000個/cm3上のイオン濃度のプラズマクラスターを毎日運転することで、繁殖のスピードが速い「ピンクぬめりの原因菌」を除菌します。
ピンクぬめりの原因菌を除菌
ピンクぬめりの原因菌を除菌
2)空気中に浮遊するカビ菌※6を除菌
浴室内においてカビのもとにもなりやすい、空気中に浮遊するしつこい汚れのもと「浮遊カビ菌」を、乾燥運転時にプラズマクラスターイオンを放出して除菌します。
3)衣類に付いたタバコ臭※7を消臭
浴室で衣類を干す際、気になる衣類についたタバコ臭も、プラズマクラスターが分解して消臭します。
4)「静電気」※8除去効果
「+」と「-」両方の静電気を低減し、静電気が気になる冬の時期に衣類の静電気を抑えることができます。
「リンナイアプリ」対応 スマートフォンから遠隔操作可能
「リンナイアプリ」を使って外出先からも、家じゅうどこにいても浴室暖房乾燥機を遠隔操作したり、常に運転状態を確認したりすることができます。
 リンナイアプリ
リンナイアプリ
ラインアップ
詳しくは当社ウェブサイトをご覧ください。
https://www.rinnai.co.jp/releases/2023/0712/index_1.html
※1 プラズマクラスターロゴ(図形)およびプラズマクラスター、Plasmacluster はシャープ株式会社の登録商標です。乾燥運転時にプラズマクラスターイオンを放出します。
※2 自動連動機能を設定した場合、おすすめの表示はされません
※3 従来機種:RBH-W414KP
※4 当技術マークのイオン個数の目安は、商品を1.6m×1.6m×高さ2.3mの浴室の壁に設置して、「浴室イオン」運転時に浴室内27点(浴室サイズを各4分割した交点)の平均で1cm3当たり25,000個以上です
※5 リンナイ(株)調べ ●試験方法:ピンクぬめりの原因菌を付着させた試験片を、浴室床面の排水口に配置して、浴室イオンコースを毎日繰り返して試験実施(菌数測定はNPO法人カビ相談センターに委託) ●対象:付着した1種類のカビ菌 ●試験結果:3日目に99%の抑制効果を確認
※6 ●試験機関:一般財団法人 石川県予防医学協会 ●試験方法:浴室にネプライザー(噴霧装置)でカビ菌を浮遊させ、エアーサンプラー(空中浮遊菌測定器)を設置して浮遊カビ菌を回収後、培養してカビ菌数を測定。浴室イオンコース(プラズマクラスターイオン循環)で実施 ●対象:浮遊した1種類のカビ菌 ●試験結果:約40分で99%の抑制 ●試験番号:第S2300219-001号
※7 リンナイ(株)調べ ●試験方法:タバコ臭を付着させた試験片で消臭効果を6段階臭気強度表示法にて評価 ●試験結果:衣類イオンコースを運転後、60分で気にならないレベルまで消臭。※においの種類・強さ・対象物の素材などにより消臭効果は異なります
※8 リンナイ(株)調べ ●試験方法:1kVに帯電させた試験板を、0.1kVまで除電するのに要した時間を確認。(参考:JIS C 61340-4-7:2011 静電気―第4-7部:特定応用のための標準的試験方法―イオナイザ) ●試験結果:衣類イオンコースを運転後、約7秒で0.1kVまで除電。※効果はご使用環境やご使用方法により異なります
このプレスリリースには、メディア関係者向けの情報があります
メディアユーザー登録を行うと、企業担当者の連絡先や、イベント・記者会見の情報など様々な特記情報を閲覧できます。※内容はプレスリリースにより異なります。
すべての画像
